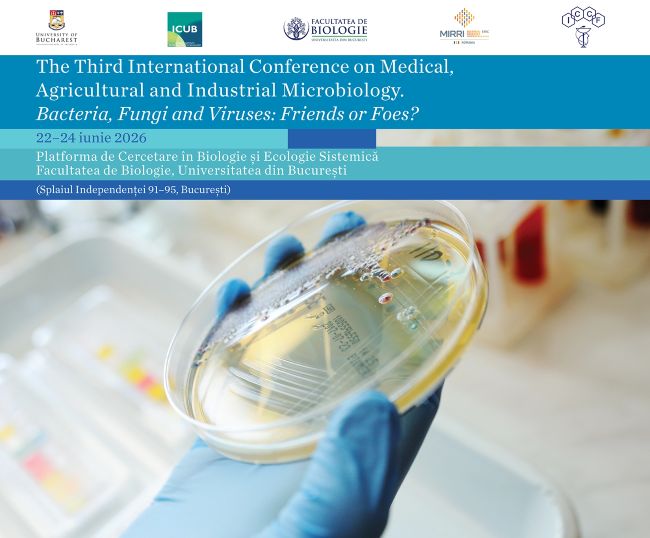

(English version below)
Universitatea din București anunță “The Third International Conference on Medical, Agricultural and Industrial Microbiology. Bacteria, Fungi and Viruses: Friends or Foes?”.
Organizată în perioada 22–24 iunie 2026 de Facultatea de Biologie și Institutul de Cercetare al Universității din București (ICUB), în parteneriat cu MIRRI-ERIC (Microbial Resource Research Infrastructure – European Research Infrastructure Consortium) și Institutul Național de Cercetare-Dezvoltare Chimico-Farmaceutică (ICCF) București, conferința se constituie într-un forum interdisciplinar pentru explorarea modului în care progresele din cercetarea microbiană se transpun din mediul academic în aplicații practice.
În cadrul evenimentului, participanții vor analiza rolul dual al microbilor – atât ca parteneri benefici în biotehnologie, cât și ca agenți patogeni care afectează sănătatea umană și agricultura.
Programul va include keynote speakers de talie internațională, workshop-uri interactive și sesiuni de prezentări orale și postere. Acestea sunt concepute pentru a stimula stabilirea de conexiuni, colaborarea globală și schimbul de informații privind cele mai recente descoperiri în științele microbiene.
Conferința se adresează cercetătorilor și profesorilor, dar și studenților, masteranzilor și doctoranzilor care dețin rezultate relevante în domeniile conferinței.
Evenimentul va avea loc la Platforma de Cercetare în Biologie și Ecologie Sistemică (Splaiul Independenței 91-95, București) din cadrul Facultății de Biologie a UB. Informații detaliate privind înscrierea, programul și desfășurarea conferinței vor fi publicate în perioada imediat următoare.
Pre-înregistrarea și detalii suplimentare sunt disponibile la adresa: events@icub.unibuc.ro.
UB announces „The Third International Conference on Medical, Agricultural and Industrial Microbiology. Bacteria, Fungi and Viruses: Friends or Foes?”, organized between 22–24 June 2026
The University of Bucharest announces „The Third International Conference on Medical, Agricultural and Industrial Microbiology. Bacteria, Fungi and Viruses: Friends or Foes?”.
Organized between 22 and 24 June 2026 by the Faculty of Biology and the Research Institute of the University of Bucharest (ICUB), in partnership with MIRRI-ERIC (Microbial Resource Research Infrastructure – European Research Infrastructure Consortium) and the National Institute for Chemical-Pharmaceutical Research and Development (ICCF) Bucharest, the conference provides an interdisciplinary forum to explore how advances in microbial research translate from academia into real-world applications.
Within the event, participants will examine the dual role of microbes — as beneficial partners in biotechnology and as disease-causing agents affecting human health and agriculture.
The program will feature international keynote speakers, interactive workshops, and poster and oral presentation sessions, designed to foster networking, global collaboration, and the exchange of the latest developments in microbial sciences.
The conference welcomes researchers and professors, but also undergraduate and graduate students with relevant results in the fields.
The event will take place at the Platform of Research in Biology and Systemic Ecology (Splaiul Independenței 91-95, Bucharest) within the Faculty of Biology of UB. Further information regarding registration, program and organization of the conference will be published in the coming days.
Pre-registration and additional details are available at events@icub.unibuc.ro.
